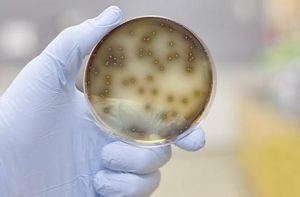
科學實驗法 科學實驗法

定義
指人們根據一定的科學研究目的,利用科學儀器設備,在人為控制或模擬的特定條件下,排除各種干擾,對研究對象進行觀察的方法。
意義和作用
1、為自然科學獲取新的、第一手資料
2、檢驗理論、假說正確性的唯一標準
3、人為控制研究對象、創造極端條件、模擬實驗對象
步驟
1、確定研究方向:考慮研究新穎性、可行性、推廣價值、成本、影響因素等
2、查閱資料(調查、採訪、參考文獻等),確定具體課題
3、設計實驗方案:時間、器材、人員、所需數據(寧多勿少)及記錄方式(表格、圖像、攝像機等)、假設結論;控制單一變數
4、進行實驗:嚴格按照科學實驗要求,真實記錄數據,同時記錄出現問題
5、分析和整理數據
6、得出結論,反思實驗過程中的不足以及可繼續探索之處
特徵
(1)有目的地操縱自變數。 研究者人為地去控制自變數的發生和發展,使實驗沿著研究者預定的方向進行從而取得自己所需要的研究結果。
(2)實驗過程控制嚴密。
排除其它無關因素的影響,控制無關因素,使實驗除了自變數以外的其它條件保持一致,這樣才能保證實驗實驗研究具有一定的效度。
(3)有嚴謹的實驗設計和程式 在研究問題、研究假設、實驗處理、被試的選擇、條件的控制、實驗設計的方式、實驗材料與工具、實驗程式等方面都要在實驗設計中明確地規定下來,只有這樣才能保證實驗結果具有科學性和有效性。
(4)可以在相同的情況下重複進行,以便驗證結果的可靠性與有效性。只要理論假設正確,設計嚴密,操作嚴謹,經過重複實驗後所得到的實驗結果應大致相同。
類型
以不同作用進行分類
1、 析因實驗 尋找引起某些變化或結果的原因
從已知的結果中去找出未知的原因 廣泛套用
2、判決實驗 判定某種假說是否正確而安排的實驗 能夠宣判一假說的前途命運 判決微觀粒子在弱相互作用下宇稱不守恆假說
3、探索實驗 創設一定的條件來達到某一目的而安排 從已知的原因來發現它將產生的未知結果 推翻了“熱素”說
4、比較(對照)實驗 兩個或兩個以上的相似組群進行比較生命科學藥品療效的試驗,農業科學研究中的田間試驗
5、中間實驗 最後確定其科研成果能否套用於生產的科學價值。 科學研究中已取得初步成效,在生產套用前必須進行模擬生產條件農業科學研究和工程技術試驗中較複雜、規模又比較大的研究項目
從結果的性質進行分類
定性實驗是指為了測定研究對象的性質及其組成部分而安排的實驗。其目的就是為了判定某種組成部分是否存在,或是否起作用。它的特點是回答“有沒有”或者“是不是”等問題。這種實驗在科學研究中經常使用。科學史上很多著名的實驗都屬於定性實驗,如戴維用氧化二氮作麻醉劑的實驗,美國科學家富蘭克林揭開雷電之謎的實驗等等。
定量實驗是指在測定研究對象的組成成分的基礎上,進一步測定各組成成分之間的數量關係,確定含有某一組成成分的數值等實驗。在化學實驗中,往往不僅要了解某一化合物的化學組分,而且在此基礎上還要進一步確定其各組分的含量,或者了解化學反應中各組分參與反應的消耗量,或者了解各組分的最佳配方比例等等。在物理學實驗中往往要確定某一物質的物理特性,如溶點、沸點、冰點以及其他一些物理學常用數值等,這些都屬於定量實驗的範圍。法國化學家拉瓦錫就是在大量定量實驗基礎上,建立氧化還原理論的。
定性實驗和定量實驗雖然是不同性質的實驗,但是它們之間又是不可割裂的。定性實驗是定量實驗的基礎,只有在確定了某一物質的組成成分以後,才能進一步測定其含有的數值。同時,也只有經過定量實驗,才能對這一物質的整體性質有所了解。因此,從定性實驗發展到定量實驗,這是認識不斷深化的表現。特別當定量實驗與數學方法相結合之後,它在科學技術發展過程中的作用日益突出,運用的範圍也日益廣泛,這是現代科學技術發展的重要特點之一。
實驗方法離不開儀器的幫助,而儀器的精密度直接影響實驗的效果,這對定量實驗尤為突出。定量實驗的精確與否,又會直接引起研究對象性質判別上的差異。
結構分析實驗是指為了測定研究對象的空間結構狀況並對其進行分析而安排的實驗。它既有定性的一面,也有定量的一面。如沃森—克里克的DNA雙螺旋結構的發現,苯結構的實驗等等,都屬於這一類。
其他分類法
按照實驗場所的不同進行分類
如地面實驗、空間實驗、地下實驗等